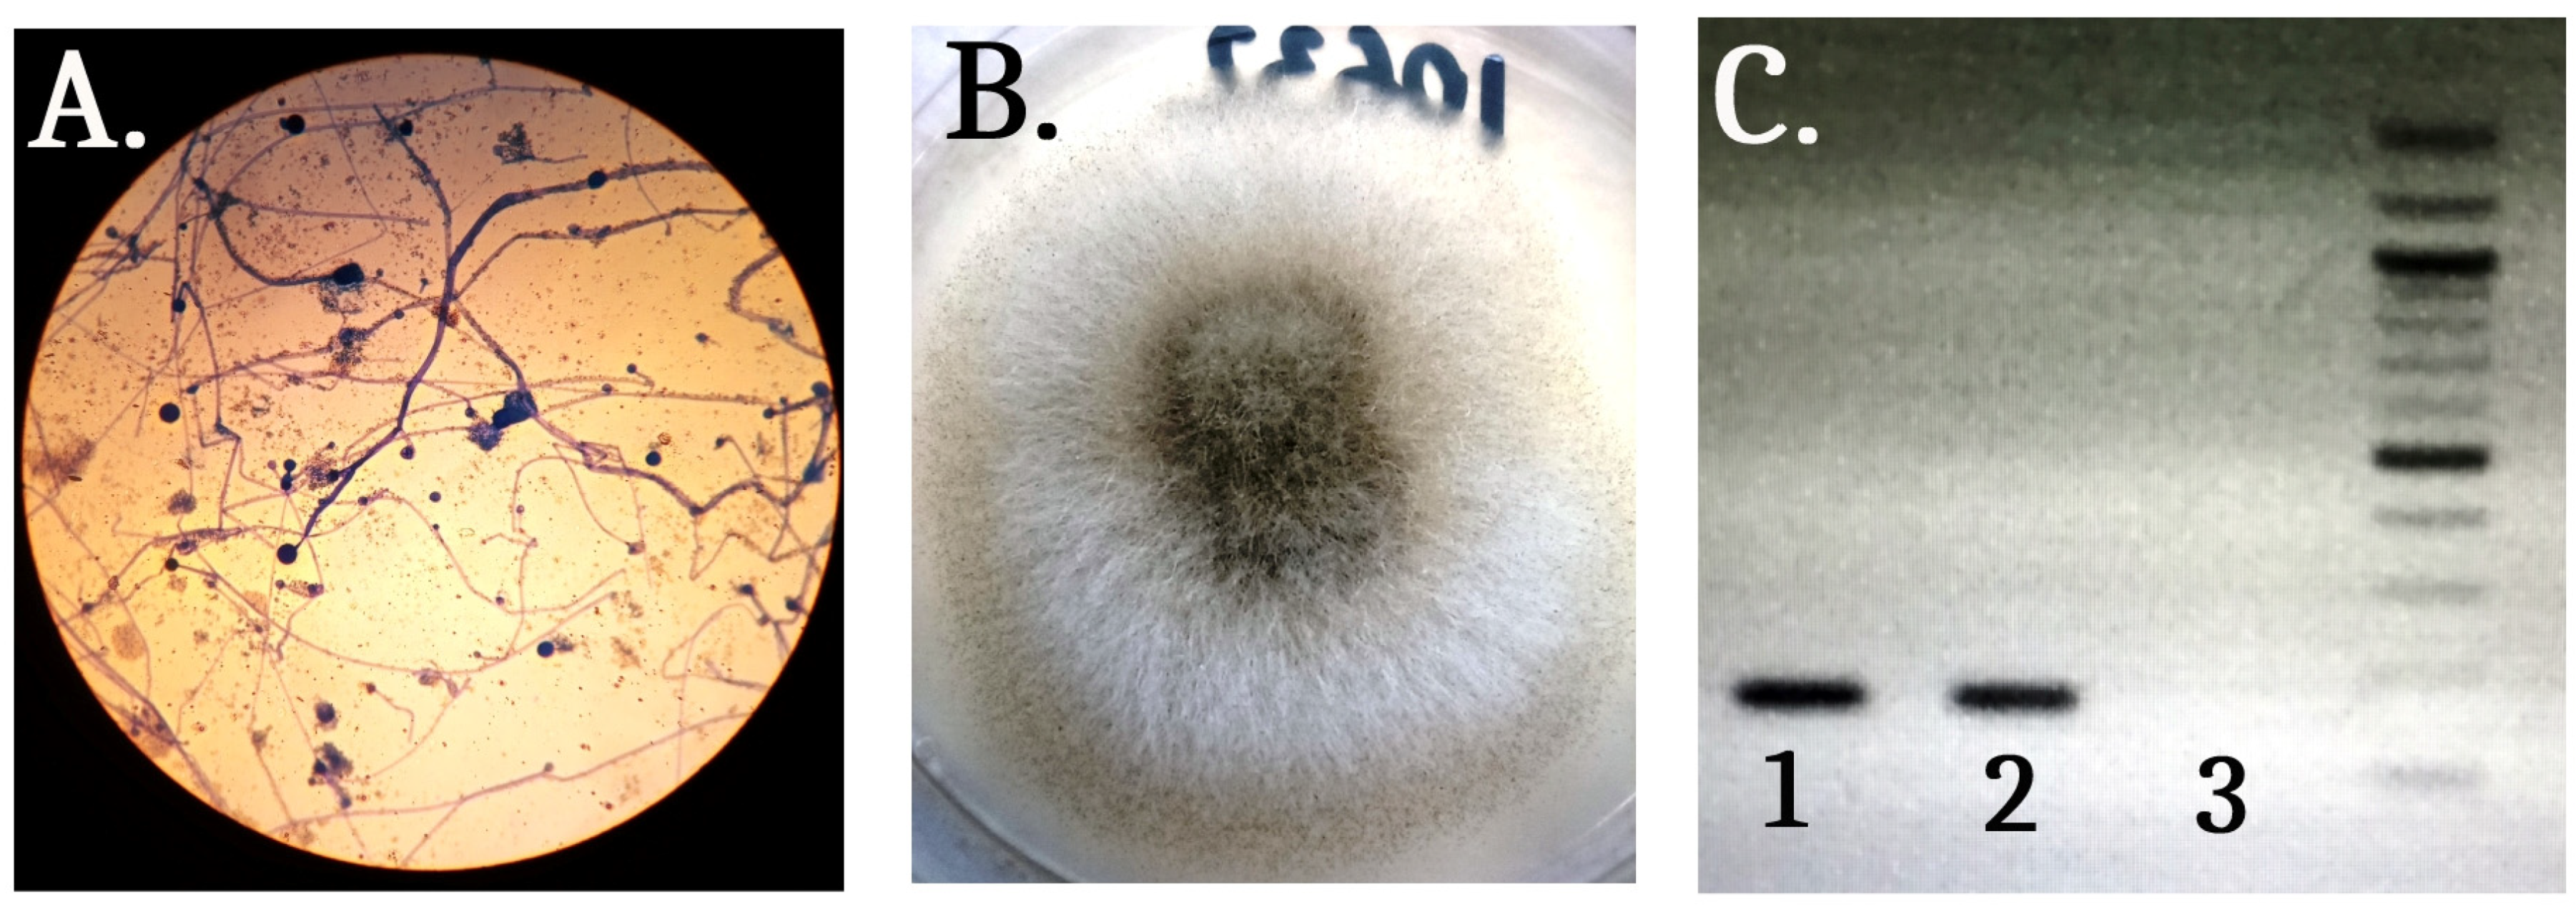
Medicina 59 00905 g002

A Case of Primary Multifocal Cutaneous Mucormycosis in a Pediatric Patient with Newly Diagnosed Acute Lymphoblastic Leukemia
Abstract
1. Introduction
2. Case Report
3. Discussion
4. Conclusions
Author Contributions
Funding
Institutional Review Board Statement
Informed Consent Statement
Data Availability Statement
Conflicts of Interest
References
- Kriengkauykiat, J.; Ito, J.I.; Dadwal, S.S. Epidemiology and treatment approaches in management of invasive fungal infections. Clin. Epidemiol. 2011, 3, 175–191. [Google Scholar] [CrossRef] [PubMed]
- Francis, J.R.; Villanueva, P.; Bryant, P.; Blyth, C.C. Mucormycosis in Children: Review and Recommendations for Management. J. Pediatric. Infect. Dis. Soc. 2018, 7, 159–164. [Google Scholar] [CrossRef]
- Paltauf, A. Mycosis mucorina . Virchows Arch. 1885, 102, 543–564. [Google Scholar] [CrossRef]
- Baker, R.D. Mucormycosis; a new disease? J. Am. Med. Assoc. 1957, 163, 805–808. [Google Scholar] [CrossRef]
- Petrikkos, G.; Skiada, A.; Lortholary, O.; Roilides, E.; Walsh, T.J.; Kontoyiannis, D.P. Epidemiology and clinical manifestations of mucormycosis. Clin. Infect. Dis. 2012, 54 (Suppl. S1), S23–S34. [Google Scholar] [CrossRef] [PubMed]
- Sirignano, S.; Blake, P.; Turrentine, J.E.; Dominguez, A.R. Primary cutaneous zygomycosis secondary to minor trauma in an immunocompromised pediatric patient: A case report. Dermatol. Online J. 2014, 20, 13030. [Google Scholar] [CrossRef]
- Hofman, V.; Dhouibi, A.; Butori, C.; Padovani, B.; Gari-Toussaint, M.; Garcia-Hermoso, D.; Baumann, M.; Vénissac, N.; Cathomas, G.; Hofman, P. Usefulness of molecular biology performed with formaldehyde-fixed paraffin embedded tissue for the diagnosis of combined pulmonary invasive mucormycosis and aspergillosis in an immunocompromised patient. Diagn. Pathol. 2010, 8, 1. [Google Scholar] [CrossRef] [PubMed]
- Donnelly, J.P.; Chen, S.C.; Kauffman, C.A.; Steinbach, W.J.; Baddley, J.W.; Verweij, P.E.; Clancy, C.J.; Wingard, J.R.; Baddley, J.W.; Verweij, P.E.; et al. Revision and Update of the Consensus Definitions of Invasive Fungal Disease from the European Organization for Research and Treatment of Cancer and the Mycoses Study Group Education and Research Consortium. Clin. Infect. Dis. 2020, 71, 1367–1376. [Google Scholar] [CrossRef] [PubMed]
- Elitzur, S.; Arad-Cohen, N.; Barg, A.; Litichever, N.; Bielorai, B.; Elhasid, R.; Fischer, S.; Fruchtman, Y.; Fruchtman, Y.; Gilad, G.; et al. Mucormycosis in children with haematological malignancies is a salvageable disease: A report from the Israeli Study Group of Childhood Leukemia. Br. J. Haematol. 2020, 189, 339–350. [Google Scholar] [CrossRef]
- Pana, Z.D.; Seidel, D.; Skiada, A.; Groll, A.H.; Petrikkos, G.; Cornely, O.A.; Roilides, E. Invasive mucormycosis in children: An epidemiologic study in European and non-European countries based on two registries. BMC Infect. Dis. 2016, 16, 667. [Google Scholar] [CrossRef]
- Rees, J.R.; Pinner, R.W.; Hajjeh, R.A.; Brandt, M.E.; Reingold, A.L. The epidemiological features of invasive mycotic infections in the San Francisco Bay area, 1992–1993: Results of population-based laboratory active surveillance. Clin. Infect. Dis. 1998, 27, 1138–1147. [Google Scholar] [CrossRef]
- Skiada, A.; Lass-Floerl, C.; Klimko, N.; Ibrahim, A.; Roilides, E.; Petrikkos, G. Challenges in the diagnosis and treatment of mucormycosis. Med. Mycol. 2018, 56, S93–S101. [Google Scholar] [CrossRef] [PubMed]
- Chakrabarti, A.; Singh, R. Mucormycosis in India: Unique features. Mycoses 2014, 57, S85–S90. [Google Scholar] [CrossRef] [PubMed]
- Bonifaz, A.; Tirado-Sánchez, A.; Calderón, L.; Ponce, R.M. Cutaneous Mucormycosis: Mycological, Clinical, and Therapeutic Aspects. Curr. Fungal Infect. Rep. 2015, 9, 229–237. [Google Scholar] [CrossRef]
- Steinbrink, J.M.; Miceli, M.H. Mucormycosis. Infect. Dis. Clin. N. Am. 2021, 35, 435–452. [Google Scholar] [CrossRef]
- Albízuri-Prado, M.F.; Sánchez-Orta, A.; Rodríguez-Bandera, A.; Feito-Rodríguez, M. Primary Cutaneous Mucormycosis Due to Rhizopus arrhizus in an 8-Year-Old Girl. Mucormicosis cutánea primaria por Rhizopus arrhizus en una niña de 8 años. Actas Dermo-Sifiliogr. 2018, 109, 562–564. [Google Scholar] [CrossRef]
- Chakravarti, A.; Bhargava, R.; Bhattacharya, S. Cutaneous mucormycosis of nose and facial region in children: A case series. Int. J. Pediatr. Otorhinolaryngol. 2013, 77, 869–872. [Google Scholar] [CrossRef]
- Cantatore-Francis, J.L.; Shin, H.T.; Heilman, E.; Glick, S.A. Primary cutaneous zygomycosis in two immunocompromised children. Pediatr. Dermatol. 2007, 24, 257–262. [Google Scholar] [CrossRef]
- Cornely, O.A.; Alastruey-Izquierdo, A.; Arenz, D.; Chen, S.C.A.; Dannaoui, E.; Hochhegger, B.; Hoenigl, M.; Jensen, H.E.; Lagrou, K.; Lewis, R.E.; et al. Global guideline for the diagnosis and management of mucormycosis: An initiative of the European Confederation of Medical Mycology in cooperation with the Mycoses Study Group Education and Research Consortium. Lancet Infect. Dis. 2019, 19, e405–e421. [Google Scholar] [CrossRef]
- Zayet, S.; Zaghdoudi, A.; Ammari, L.; Kilani, B.; Tiouiri Benaissa, H. Cerebro-rhino-orbital mucormycosis and aspergillosis coinfection in a patient with diabetes mellitus: A case report. IDCases 2020, 23, e01022. [Google Scholar] [CrossRef]
- Pagano, L.; Offidani, M.; Fianchi, L.; Nosari, A.; Candoni, A.; Picardi, M.; Corvatta, L.; D’Antonio, D.; Girmenia, C.; Martino, P.; et al. Mucormycosis in hematologic patients. Haematologica 2004, 89, 207–214. [Google Scholar] [PubMed]
- Carvalhaes, C.G.; Rhomberg, P.R.; Huband, M.D.; Pfaller, M.A.; Castanheira, M. Antifungal Activity of Isavuconazole and Comparator Agents against Contemporaneous Mucorales Isolates from USA, Europe, and Asia-Pacific. J. Fungi 2023, 9, 241. [Google Scholar] [CrossRef] [PubMed]
- Dagher, H.; Hachem, R.; Chaftari, A.-M.; Jiang, Y.; Ali, S.; Deeba, R.; Shah, S.; Raad, I. Real-World Use of Isavuconazole as Primary Therapy for Invasive Fungal Infections in High-Risk Patients with Hematologic Malignancy or Stem Cell Transplant. J. Fungi 2022, 8, 74. [Google Scholar] [CrossRef] [PubMed]
- Kontoyiannis, D.P.; Lionakis, M.S.; Lewis, R.E.; Chamilos, G.; Healy, M.; Perego, C.; Safdar, A.; Kantarjian, H.; Champlin, R.; Walsh, T.J.; et al. Zygomycosis in a tertiary-care cancer center in the era of Aspergillus-active antifungal therapy: A case-control observational study of 27 recent cases. J. Infect. Dis. 2005, 191, 1350–1360. [Google Scholar] [CrossRef]
- Skiada, A.; Drogari-Apiranthitou, M.; Pavleas, I.; Daikou, E.; Petrikkos, G. Global Cutaneous Mucormycosis: A Systematic Review. J. Fungi 2022, 8, 194. [Google Scholar] [CrossRef]

| Laboratory Blood Test Results | At Admission | During Hospital Stay |
|---|---|---|
| Hemoglobin, g/L (130–180) | 56 | 65–126 |
| WBC, 109/L (4–10) | 5.7 | 0.2–10 |
| Platelets, 109/L (140–440) | 19 | 7–324 |
| Glucose, mmol/L (3.9–5.5) | 4.9 | 4.5–9.1 |
| Fibrinogen, g/L (2–4) | 2.35 | 0.89–1.72 |
Disclaimer/Publisher’s Note: The statements, opinions and data contained in all publications are solely those of the individual author(s) and contributor(s) and not of MDPI and/or the editor(s). MDPI and/or the editor(s) disclaim responsibility for any injury to people or property resulting from any ideas, methods, instructions or products referred to in the content. |
© 2023 by the authors. Licensee MDPI, Basel, Switzerland. This article is an open access article distributed under the terms and conditions of the Creative Commons Attribution (CC BY) license (https://creativecommons.org/licenses/by/4.0/).
Share and Cite
Niyazi, D.; Belcheva, M.; Vergiev, S.; Kaleva, V.; Stoeva, T. A Case of Primary Multifocal Cutaneous Mucormycosis in a Pediatric Patient with Newly Diagnosed Acute Lymphoblastic Leukemia. Medicina 2023, 59, 905. https://doi.org/10.3390/medicina59050905
Niyazi D, Belcheva M, Vergiev S, Kaleva V, Stoeva T. A Case of Primary Multifocal Cutaneous Mucormycosis in a Pediatric Patient with Newly Diagnosed Acute Lymphoblastic Leukemia. Medicina. 2023; 59(5):905. https://doi.org/10.3390/medicina59050905
Chicago/Turabian StyleNiyazi, Denis, Milena Belcheva, Stoyan Vergiev, Valeria Kaleva, and Temenuga Stoeva. 2023. "A Case of Primary Multifocal Cutaneous Mucormycosis in a Pediatric Patient with Newly Diagnosed Acute Lymphoblastic Leukemia" Medicina 59, no. 5: 905. https://doi.org/10.3390/medicina59050905
APA StyleNiyazi, D., Belcheva, M., Vergiev, S., Kaleva, V., & Stoeva, T. (2023). A Case of Primary Multifocal Cutaneous Mucormycosis in a Pediatric Patient with Newly Diagnosed Acute Lymphoblastic Leukemia. Medicina, 59(5), 905. https://doi.org/10.3390/medicina59050905

